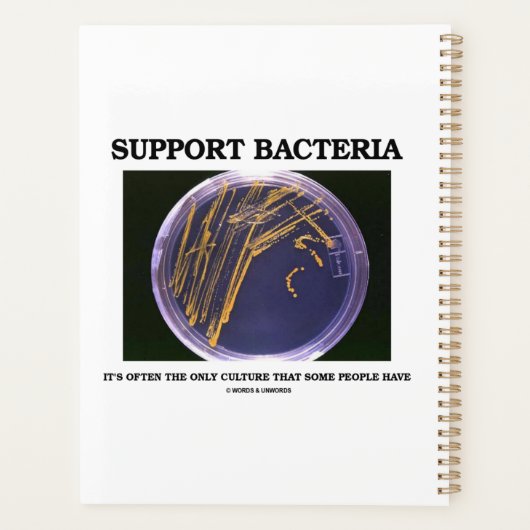
細菌を支持する場合は一部の人しか培養しない プランナー手帳 (裏面)

プランナー手帳について
販売:
このデザインについて
細菌を支持する場合は一部の人しか培養しない プランナー手帳
細菌のコロニーを持つ寒天プレートを含むこの舌の科学ことわざプランナーに楽しむは、細菌学者、微生物学者、生物学者である必要はない。 ことわざは全てを言う:"バクテリアを支える – 一部の人々が持っている唯一の文化である場合が多い"。 文化の主題に関するこのダブルエンテンダーなユーモアことわざプランナーで他の人をダブルテイク!
自動翻訳
カスタマーレビュー
この商品についてのレビューは、まだありません。この商品を購入しましたか?
タグ
その他の情報
商品 ID: 256305183290094458
出品日: 2022/5/20 4:14
レーティング: G
最近閲覧された商品